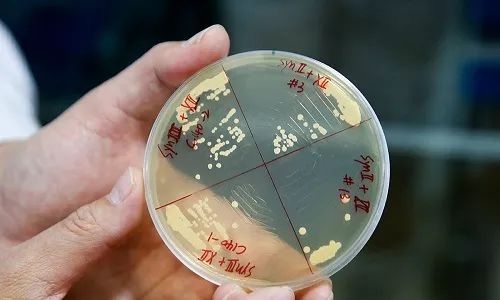

海关大数据锁定“洋垃圾”走私;俄罗斯用AI预测人是否会早死
【数据猿导读】借助大数据管控,中江高速超限超载车辆下降84%;俄科学家利用人工智能预测人是否会早死;百度再爆医疗竞价排名,百度搜索总裁向海龙回应
编辑 | sharon
官网 | www.datayuan.cn
微信公众号ID | datayuancn
一、借助大数据管控,中江高速超限超载车辆下降84%
今年4月中江高速因借助大数据和互联网技术,从源头对超限超载车辆进行管控,全线各收费站出入口处理超限超载车辆数量同比下降84%。
二、大数据分析,上海海关锁定“洋垃圾”走私
上海海关通过大数据分析发现,上海某贸易有限公司等自去年10月以来,涉嫌以伪报品名方式走私进口废塑料2.8万余吨。从5月21日晚至22日凌晨,上海海关成功抓捕5名嫌疑人。
三、人工智能首次设计出工业菌株
中国科学院微生物研究所吴边团队通过智能计算技术,创造出自然界中不存在的生物催化反应类型,并在世界上首次通过计算指导完成工业级菌株的构建。
四、俄科学家利用人工智能预测人是否会早死
据俄《共青团真理报》消息,莫斯科物理技术学院与生物初创公司“Gero”的科研人员合作研发了一种可以预测人过早死亡的技术。
五、阿里AI收银员:49秒可点34杯咖啡
5月23日,阿里云在“云栖大会·武汉峰会”展示了AI点餐技术,不需要唤醒词,49秒可点34杯咖啡,人工点一杯咖啡则需两分半。
六、工信部工业经济研究所所长于佳宁:区块链对实体经济效用明显
5月22日,工信部工业经济研究所所长于佳宁在央广TMT沙龙上表示,区块链对实体经济效果明显,体现在降成本,提升效率,优化协同环境,引导资金脱虚入实几个方面。
七、百度再爆医疗竞价排名,百度搜索总裁向海龙回应
百度高级副总裁、百度搜索公司总裁向海龙回应医疗竞价排名,“百度坚决不允许医院以”三甲医院’的名义及名称投放广告。”
八、扎克伯格在欧洲议会接受询问,再次为数据泄露道歉
扎克伯格周二在欧洲议会接受询问,就该社交媒体上个人数据遭到滥用向议员们做出解释,并就剑桥分析以不当方式获取8700万Facebook用户数据一事向欧洲议会表示道歉。
九、沃尔玛申请区块链新专利,跟踪零售商品销售
上周四,沃尔玛向美国专利和商标局提交的最新的专利申请文件,概述了一项可以追踪商店出售给特定客户的商品的区块链分布式账本。
十、三星将在剑桥大学设AI中心,招募150名AI专家
5月23日消息,三星将在英国名校剑桥大学设立一家新的AI研究中心,未来可能会招募150名AI专家。
十一、听闻FM旗下“听闻区块链”获800万元天使轮融资
听闻区块链是听闻FM旗下的新事业部,2018年3月份开始内部孵化,目前覆盖了近500万的区块链用户。
6月12日,数字资产投资峰会:金融科技区块链支持可持续发展-北京站即将开始,期待我们的见面👇